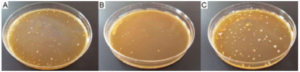

Drobnoustroje probiotyczne wykazują w organizmie szereg bardzo ważnych funkcji, wpływając poprzez to na prawidłowe funkcjonowanie organizmu człowieka. Mechanizmy ich działania w organizmie nie zostały jak dotąd dostatecznie wyjaśnione. Należy jednak zwrócić uwagę na fakt, że pozytywny wpływ mikroorganizmów probiotycznych zawdzięczamy nie tylko ich bezpośredniej obecności, a także produktom ich metabolizmu – POSTBIOTYKOM. Postbiotyki to substancje produkowane przez probiotyczne mikroorganizmy, wykazujące bezpośrednie lub pośrednie działanie prozdrowotne, m. in. bakterio-, grzybo- i pleśniobójcze. Odnaleźć je można w płynnych preparatach probiotycznych.
Każda grupa drobnoustrojów charakteryzuje się określonym profilem postbiotyków (metabolitów), który wynika z ich metabolizmu. Drobnoustroje pobierają składniki odżywcze z podłoża w celu zachowania procesów życiowych, w tym rozmnażania. Metabolizując składniki pożywki syntetyzują metabolity takie jak kwasy organiczne, alkohole czy glicerol, nazwane postbiotykami. Postbiotyki wydzielane na zewnątrz komórki są wykorzystywane przez drobnoustroje zdolne do ich produkcji, jako element systemu chroniącego komórkę lub zapewniającego homeostazę. Obecność postbiotyków wytwarzanych przez drobnoustroje probiotyczne w gotowych produktach ma istotne znaczenie w aspekcie ich biofunkcjonalności, a także gwarantuje ich stabilność i trwałość.
Do głównych postbiotyków drobnoustrojów probiotycznych zaliczamy kwas mlekowy, octowy i propionowy, stanowiące produkty homo- i heterofermentacji mlekowej. Najsilniejszymi właściwościami hamującymi rozwój drobnoustrojów charakteryzuje się kwas octowy. Skutecznie hamuje wzrost bakterii, pleśni i drożdży. Działanie kwasów organicznych w znacznym stopniu polega na obniżaniu pH środowiska do poziomu niekorzystnego dla patogenów, a także na zaburzaniu procesów metabolicznych zachodzących w komórkach drobnoustrojów niepożądanych oraz transportu aktywnego przez błony komórkowe.
Innym ważnym postbiotykiem jest diacetyl. Jest to lotny, niepolarny diketon powstający z rozkładu pirogronianu. Wytwarzany jest przez niektóre szczepy z rodzaju Lactobacillus, Leuconostoc oraz Streptococcus. Wykazuje właściwości bakteriobójcze względem niektórych gram-ujemnych bakterii przez inaktywację szlaku metabolicznego argininy. W warunkach tlenowych bakterie mlekowe produkują także nadtlenek wodoru, którego obecność stanowi efekt działania oksydazy flawoproteinowej oraz peroksydazy NADH. Związek posiada silne właściwości antymikrobiologiczne, polegające na denaturacji enzymów komórkowych i peroksydacji lipidów błonowych, tym samym prowadząc do zaburzenia czynności błon komórkowych oraz zatrzymania wielu szlaków metabolicznych. Kolejnym istotnym postbiotykiem jest ditlenek węgla, który stanowi produkt uboczny heterofermentacji mlekowej, a wykazuje działanie bakteriobójcze, szczególnie przeciwko bakteriom gram-ujemnym. Bakteriocyny są substancjami o charakterze białkowym lub peptydowym, syntetyzowanymi przez większość szczepów bakterii, zarówno gram-dodatnich oraz gram-ujemnych. Synteza bakteriocyn ma miejsce w rybosomach, a bakteriocynogenne mikroorganizmy są odporne na wytwarzane przez siebie substancje.
Skład ilościowy i jakościowy produktów probiotycznych oznaczano techniką wysokosprawnej chromatografii cieczowej (HPLC) z wykorzystaniem chromatografu Agilent Technologies 1200 series. W skład układu chromatografu wchodził: automatyczny podajnik prób G1329B, podwójna pompa G1312B z detektorem refraktometrycznym G1362A. Rozdziału dokonywano na kolumnie Rezex ROA. Na kolumnę nanoszono 10 μL próby, fazę ruchomą stanowił 0,005 N H2SO4. Szybkość przepływu wynosiła 0,6 ml/min w temperaturze 40oC. Identyfikację oznaczanych związków chemicznych przeprowadzono metodą standardu zewnętrznego, mierząc pole powierzchni pod pikami (pomiar i integracja komputerowa z zastosowaniem ChemStation for LC 3D systems, Agilent).

W płynnych produktach probiotycznych stwierdzono obecność 11 związków wykazujących prozdrowotne i antyseptyczne właściwości: kwas walerianowy, kwas heptanowy, kwas octowy, kwas benzoesowy, ester etylowy, ester 2-metylobytylowy, ester 2-etyloheksylowy, ester metylowy, aldehyd benzoesowy, 1,2-propanediol i dodekalnol.
Aktywność antagonistyczna bakterii probiotycznych jest ściśle związana z syntezą specyficznych produktów hamujących wzrost niepożądanych drobnoustrojów (m.in. kwasów organicznych), które działają synergistycznie.
Należy zaznaczyć, że aktywność przeciwdrobnoustrojowa bakterii jest cechą szczepozależną, wynikającą ze specyficznej interakcji między szczepem bakteryjnym a szczepem wskaźnikowym. Mechanizm aktywności antagonistycznej bakterii probiotycznych nie jest dokładnie poznany. Przypuszcza się, że polega on na zmianie warunków środowiska pod wpływem wytwarzania kwasów organicznych i innych postbiotyków niekorzystnych dla wzrostu drobnoustrojów niepożądanych. Do takich czynników środowiskowych należą: temperatura, pH, skład podłoża, przy których bakterie mlekowe wytwarzają produkty o aktywności przeciwgrzybowej i przeciwbakteryjnej.
W celu oznaczenia antagonizmu produktów zawierających drobnoustroje probiotyczne względem mikroorganizmów wskaźnikowych przeprowadzono badania, które obejmowały przygotowanie mikroorganizmów wskaźnikowych i badanie aktywności izolatów metodą studzienkową. W testach wykorzystano mikroorganizmy wskaźnikowe wymienione w tabeli poniżej. Szczepy wskaźnikowe przeniesiono do próbówek zawierających 10 ml podłoża bulionowego z dodatkiem 2% glukozy (w celu namnożenia biomasy). Hodowle prowadzono w temperaturze 37°C przez 24 godziny. Następnie w celu uzyskania wyraźnej warstwy murawkowej, upłynnione podłoże agarowe zaszczepiono 10% (v/v) 24-godzinną hodowlą kultury wskaźnikowej i wylano na płytki Petriego. Na powierzchnię stałej pożywki zaszczepionej mikroorganizmami wskaźnikowymi nanoszono punktowo 20 μL badanego produktu. Inkubację prowadzono w 37°C przez 24 godziny, w warunkach beztlenowych lub względnie beztlenowych. Następnie mierzono średnice strefy zahamowania lub ograniczenia wzrostu bakterii wskaźnikowych. Zahamowanie wzrostu mikroorganizmu wskaźnikowego, przejawiające się całkowitym przejaśnieniem wokół miejsca naniesienia płynu hodowlanego świadczyło o aktywności bakteriobójczej badanego szczepu. O właściwościach bakteriostatycznych orzekano na podstawie zmniejszenia gęstości murawki (ograniczenie wzrostu szczepu wskaźnikowego).
Tabela 1. Aktywność antymikrobiologiczna produktów wobec drobnoustrojów wskaźnikowych
| per 100 ml | per serving 125 ml | % RWS* | ||
|---|---|---|---|---|
| energy | 36 kJ/8 kcal | 45 kJ/10 kcal | 0% | |
| fat | 0 g | 0 g | 0% | |
| including saturated fatty acids | 0 g | 0 g | 0% | |
| carbohydrates | 2,1 g | 2,6 g | 0% | |
| including sugars | 0 g | 0 g | 0% | |
| fiber | 0 g | 0 g | – | |
| protein | 0 g | 0 g | 0% | |
| salt | <0,02 g | <0,02 g | 0% |
Legenda: *produkt probiotyczny zawierający biomasę bakterii probiotycznych wraz z ich metabolitami; **płyn pofermentacyjny pozbawiony biomasy bakterii probiotycznych
Płynne produkty probiotyczne wykazują największą aktywność antybakteryjną wobec bakterii z gatunku Listeria monocytogenes, Escherichia coli i Salmonella typhimurium.
Płynne produkty probiotyczne wykazują największą aktywność antygrzybową wobec drożdży z gatunku Candida albicans.
Największą aktywność antymikrobioloiczną wykazują płynne produkty probiotyczne zawierające biomasę bakterii probiotycznych wraz z ich metabolitami.
Źródło: Badania nad oceną jakości i biofunkcjonalności produktów probiotycznych firmy Living Food Sp. z o.o.. Monografia Naukowa, 2019.